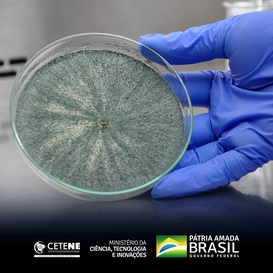

Notícias
CETENE desenvolve pesquisa em biocontrole de nematoides de importância agrícola

Vamos conhecer os pesquisadores do CETENE?
Ana Maria Maciel é engenheira agrônoma e doutora em Melhoramento Genético de Plantas, formada pela Universidade Federal Rural de Pernambuco (UFRPE). Possui experiência nas áreas de melhoramento genético de olerícolas (com ênfase em resistência a doenças), estatística experimental, bioquímica vegetal, nutrição mineral de plantas, técnicas de hidroponia e olericultura.
No CETENE/MCTI, Ana Maria Maciel é bolsista do Programa de Capacitação Institucional (PCI) e integrante do grupo de Controle Biológico de Fitonematoides, ligado à macro área de Biotecnologia e supervisionado pela Tecnologista Bianca Galúcio. Atua no desenvolvimento de bionematicida que possa ser utilizado no manejo integrado de nematoides em culturas de importância agrícola para o Brasil.
O controle do nematoide é complexo, e quando presente no solo de determinada área é praticamente impossível sua erradicação, sendo necessária a adoção de medidas de controle. São diversos os tipos de controle do nematoide, sendo um deles o controle biológico, que está ganhando mais destaque a cada dia devido a sua eficiência e sustentabilidade. Os principais agentes de controle biológico de fitonematoides são os fungos e bactérias. Desta forma, a utilização de fungos nematófagos no controle dos nematoides das galhas é uma opção que deve ser adotada no manejo da doença.
O principal objetivo do projeto desenvolvido por Ana Maciel é realizar o isolamento de fungos, em solos de diferentes estados do Nordeste, capazes de reduzir a população de nematoides das galhas visando à produção de um bionematicida comercial e a manutenção de uma coleção de fungos nematófagos no CETENE/MCTI.
“Este projeto pode trazer grandes benefícios para a região Nordeste e para o país como um todo. Atualmente, o trabalho das empresas no biocontrole de nematoides está focado nas regiões Sul e Sudeste do país, havendo uma carência na região Nordeste. A obtenção dessa coleção de fungos será estrategicamente positiva para atrair empresas que invistam na nossa região”, comenta Ana Maria Maciel.